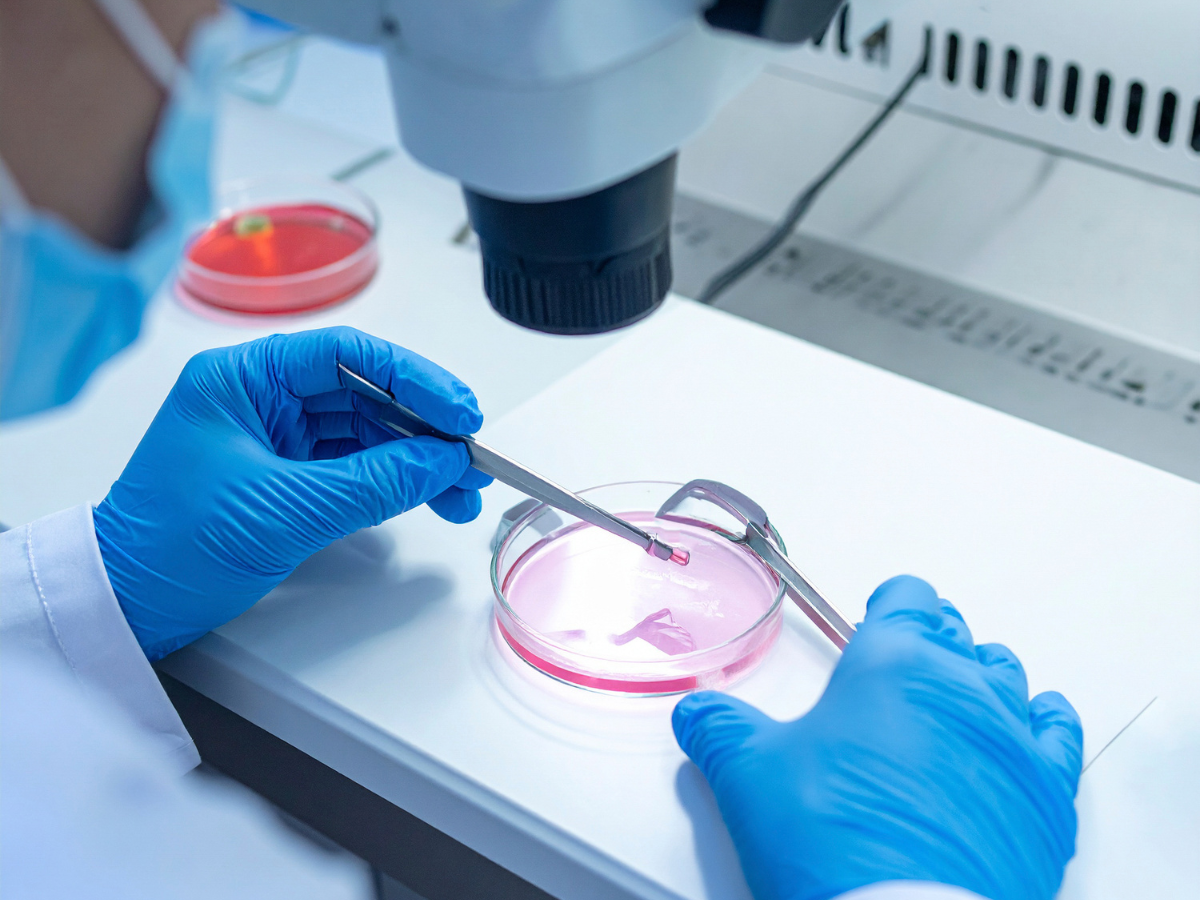
embryo selecteren

Mijn artikelen

Charlotte ziet op de kinder-IC elke dag hoe kwetsbaar een kinderleven is: nu komt ze samen met collega’s in actie

Dit moet je weten over zwangerschaps- en ouderschapsverlof in 2026

Melanie had een postnatale depressie en een huilbaby: “Zonder dat heldere moment, had ik hem uit het raam laten vallen”

Van fruithap naar… dit? Deze nieuwe babytrend zorgt voor discussie

Minder werken of kinderopvang betalen? Dit is wat je écht overhoudt

Michelle Carolina Walk straalt met nieuwe liefde in intieme foto’s

Hoogzwanger op de rode loper: Jennifer Hoffman laat zien hoe het moet

Pasgeboren baby overlijdt na ziekenhuisfout: ontsmettingsmiddel toegediend

“Hij herkent me niet”: Lil Kleine ziet zoon al 2,5 jaar niet

Het Huishoudboekje van Naomi (25): met een baby van 10 maanden in de schuldhulpverlening

Borstvoeding tijdens de ramadan: kan dat eigenlijk wel?

Jamie en haar gezin uit Het Roer Om belandt in een nachtmerrie: “Alles leeggeroofd”

Volgens de expert: zo wordt seks na kinderen weer leuk (ja, echt)

Artsen in het Kinderziekenhuis verwijderen deel van hersenen 9-jarige Anne: “Kan van alles gebeuren”

Dít is de opvoedstijl van Gaby Blaaser: “Lipsticks vliegen uit m’n tas”

Nieuwe docu onthult pijn moeder Vlaardings pleegmeisje: “Het zijn monsters”

“Gaan we haar nog wel terugzien?” Sara van één kilo ondergaat zware operatie in het Kinderziekenhuis

Eindelijk goed nieuws: dít ochtendritueel beschermt tegen dementie

‘Little valentine’: dit B&B-koppel verrast met babynieuws

Fors minder baby’s op de ic dankzij RS-prik

Moet je die stapel Pokémonkaarten anders bekijken? Ja, als ze déze kenmerken hebben

Je kind verkouden? Grote kans dat je dít verkeerd doet

Waarom ‘41’ nu het nieuwe ‘67’ is op het schoolplein

Dít nieuwe hulpmiddel tijdens de bevalling roept veel reacties op

Wat niemand je vertelt over gentle parenting

Babykamertrends 2026: dit wil je (en hiervan kregen moeders dus spijt)

Schokkend: dit is het oordeel over de Stint-producenten na het drama in Oss

Melanie had een prenatale depressie: “Niemand wist dat ik op de keukenvloer lag te hyperventileren”

Moeder van een peuter én olympisch kampioen: het verhaal van Francesca Lollobrigida raakt moeders over de hele wereld

Asbest gevonden in dít populaire speelgoed: wat betekent dit voor jouw kind?

Schermtijd bij je peuter? Dít verandert er ongemerkt in hun taal volgens nieuw onderzoek

Déze babynamen namen de 2000’s compleet over

Bibi Breijman en Waylon over hun moeilijkste periode samen: “Gaat ten koste van elkaar”

Opnieuw een baby overleden: grote zorgen om flesvoeding

Geen paleisuitzondering: zélfs de prinsessen moeten hieraan geloven

Dít zie je niet van Monique Hansler op tv (maar volgens Mike wel thuis)

Jade Kops (19) moet haar grootste droom loslaten: “Wilde zo graag moeder worden”

Patricia uit Married at First Sight is zwanger van haar eerste kind én verklapt het geslacht

Nieuw kabinet wil verbod op sociale media voor kinderen onder déze leeftijd

Tussen de Lakens met Marije (32): “Ik verlang soms vooral naar totale overgave”

Kinderen urenlang alleen in parkeergarage achtergelaten terwijl ouders op stap zijn

Bart (8) uit Het Kinderziekenhuis verloor zijn ledematen door een levensgevaarlijke infectie: “Moesten afscheid nemen”

Spannende week: familie Wildeman geeft update over Lukas na operatie

Love Island-baby op komst: Aleksandra deelt groot nieuws met haar volgers

Wil je zien: Jutta Leerdam en Jake Paul maken video voor hun toekomstige kinderen

Déze babyvoeding nu officieel in Nederland teruggeroepen na meldingen zieke kinderen

Slaap jij met sokken aan of uit? Dít zegt het over jouw persoonlijkheid

Sophie verloor de helft van haar tweeling: “Ik heb echt gedacht: ik wil niet meer”

Deze babynamen zijn verboden in Nederland (en ouders probeerden het serieus)

Er verandert iets belangrijks voor kinderen bij een scheiding

Dit bizarre cadeau na de bevalling gaat nu óók naar mannen (wij haken even af)

Dit doet oppassen op je kleinkinderen met je brein (en vooral als je oma bent!)

Waarom fulltime werken voor veel moeders geen optie meer voelt

Ouders opgelet: dít verandert er door het nieuwe coalitieakkoord

Felix (9) heeft onverwerkt verdriet: “Iedereen zag zijn gedrag, niemand zijn trauma”

Baby’s buiten laten slapen? “Jullie zijn niet goed wijs!”

Het Huishoudboekje van Linda en haar gezin: “Een vakantie zit er voorlopig niet in”

Dít babynieuws zag Hart van Nederland presentratice Nikki Herr niet aankomen

Sylvie Meis laat zien wie écht haar grote liefde is

Lieke Martens opnieuw zwanger: “Growing our family”

Een jaar geleden maakten ze geboortekaartjes, nu rouwkaartjes: het verhaal van baby Esmee (1) in Het Kinderziekenhuis

‘Met dat idee waren we toch niet getrouwd?’ Michelle Carolina Walk deelt kwetsbare update

Urenlang alleen gelaten: peuter (2) ’s nachts huilend gevonden

Jonge moeder laat pasgeboren baby doodgaan na bevalling in emmer

Nina Warink had dít niet verwacht na de bevalling: “Is geen grap”

Poedelnaakt of in pyjama naar bed: wat is nou echt gezonder?

Je kind zegt ‘skibidi’ en jij vraagt je af: wat is er misgegaan?

Waarom steeds meer ouders moeite hebben met het consultatiebureau

Déze babynamen kozen we tien jaar geleden massaal (…en nu niet meer)

Déze fout maken veel ouders met white noise bij hun baby

Roel en Simone uit Boer zoekt vrouw hebben babynieuws! (en Yvon Jaspers zag het totaal niet aankomen)

Mike Hansler droomt alweer van een baby (en dat ging sneller dan je denkt)

“Slaap lekker, wij zijn hier”: wat deze bikers doen voor mishandelde kinderen raakt je recht in je moederhart

Ouders in schock na zwaar ongeval met baby op kinderdagverblijf

Bso-medewerker (67) opgepakt na verdenking van ontucht en beelden van kindermisbruik: ouders in shock

Wat de familie Verleg uit Een Huis Vol Emigreert níét doet in de kraamweek (en veel ouders wel)

“Heel erg dat papa er niet is” Angst om Alex uit Over Mijn Lijk op verjaardag van zijn zoon

Geen relatie, wel een baby: zo werd Nhung Dam van Dertigers moeder

Tussen de Lakens met Hanna (30): “Lig tegenwoordig liever onder dan bovenop”

CO-melder ging af en toen ging het mis: influencer Closetvanval in ambulance

Liam (5) meegenomen door ICE na een week nog altijd niet terug bij zijn moeder: “Doodsbang”

“Dit vergeet je nooit”: het emotionele afscheid van Lisa (15) na 237 dagen in het Kinderziekenhuis

Na jaren vechten stopt 112 Vandaag-verslaggever Nadia Poeschmann met ivf: “Ik brak vanbinnen”

Na Nestlé nu ook déze babyvoeding teruggeroepen

Barbara Sloesen bevallen van zoontje, lag op de IC: “zwaarste week van ons leven”

Je tiener tot de middag laten slapen? Dit wil je weten vóór je hem wakker schudt

Dit is FAFO parenting (en grote kans dat jij het al doet!)

Wintertenen bij je kind komen vaker voor dan je denkt: zo herken je ze

Chantal Janzen ‘emotioneel labiel’ op 17e verjaardag zoon James

Pien Sanders en Jill Roord breiden hun gezin uit: “Mardy’s eerste dag thuis”

Meisje in Drenthe met spoed bij vader weggehaald vanwege verslaving aan beelden van kindermisbruik

Ouders schrikken: Nederlandse baby’s ziek na flesvoeding van Nestlé

Claude smelt tijdens babybezoek bij Suzan & Freek (en dat blijft niet onopgemerkt)

Het huis wordt nóg voller: Een huis vol emigreert-familie Verleg verwelkomt zesde kind

Het Huishoudboekje van Ellen en haar gezin van vijf: “Leven van één inkomen”

Deze schermregel geldt bij Doutzen Kroes thuis (en veel moeders twijfelen erover)

Derde kindje voor zangeres Meghan Trainor: en dit keer via een draagmoeder

11-jarige Tommy in het Kinderziekenhuis bleek doodziek: “Dachten dat hij een wat luier kind was”

Wil je zien: Simon Keizer zingt met zijn dochter tijdens lief vader-dochtermoment

Babynieuws bij het NOS Journaal: nieuwslezer Iris de Graaf in verwachting van eerste kindje

Babygeluk voor Christina Curry! (en oma Patricia kan haar geluk niet op)

Foto’s van je kind delen met een emoji? Experts zeggen: niet doen

Nieuw onderzoek: borstvoeding kan risico verlagen van deze mentale problemen bij moeders

‘Mama, jij bent ineens heel klein’: wat is Alice in Wonderland-syndroom?

Kinderen zeggen ‘GYAT’ en wij voelen ons oud: dit is wat het betekent

Slaap jij links of rechts in bed? Dit zegt het (volgens onderzoek) over je persoonlijkheid

Dagboek van psycholoog Dorien: “Ik ben ook maar een mens, soms raakt iets me”

Channah Koerten heeft een verrassing voor Nomi in Vier handen op één buik: “Ben je serieus?”

Familie Bal zet favoriete Halloween-traditie van overleden ouders voort (en dat gaat niet zonder chaos)

Michelle Bollen verandert haar achternaam: ‘Deze naam kies ik nu voor mezelf’

Winnen of gewoon plezier hebben? Steeds meer clubs halen het scorebord weg

Bas en Dominique van Utopia eindelijk in verwachting na heftig IVF-traject

Tussen de Lakens met Fleur: “Soms ben ik onzeker en neem ik niet de eerste stap”

Online nachtmerrie voor honderden meisjes: Limburger vast voor grootschalig misbruik

“Dit zie je bijna nooit”: baby Huub (een paar weken oud) geopereerd aan uitzonderlijke tumor

Mels van B. misbruikte meisje (4) terwijl ouders bij hem thuis op visite waren

Eerste Barbie met autisme op de markt in nieuwe inclusieserie

Presentatrice Hila Noorzai zwanger van eerste kind: “Groot geluk”

Dit is waarom je als moeder je goede voornemens niet volhoudt (en nee, het ligt niet aan jou)

Krachtige babynamen: stoer en tijdloos!

Vliegtickets boeken in 2026? Met deze Google Flights-hack betaal je veel minder

Waarom iedereen het ineens heeft over de 5:1-opvoedregel

“Ik dacht dat ik zwak was”: Joyce werd niet geloofd tijdens haar HG-zwangerschappen

Sneeuwballengevecht loopt fataal af: man (60) overleden, twee minderjarige jongens opgepakt

GTST-actrice Jasmine Sendar geeft lieve update over baby Jaxx: “Ligt hele dag in mijn armen”

Zó fris je de wollen kleding van je kind op in de sneeuw

Voorspelling populairste babynamen 2026: deze namen gaan we veel horen

Van Minions tot Moana: dit zijn de kinderfilms van 2026 waar we nu al naar uitkijken

Lief: Nordin sluit Channah Koerten en de kinderen weer in zijn armen na Expeditie Robinson

Het Huishoudboekje van Marjan en haar gezin van vier: “Reclamefolder zijn hier heilig”

Paniek tijdens de bevalling van Stacey in Vier Handen Op Een Buik: “Straks ga ik alleen naar huis met de baby”

Familie Kraan uit Een Huis Vol deelt update na echo: “Blijft spannend”

Gerdien Blom uit Een huis vol bevalt: ‘Zit helemaal in haar bubbel’

Jaimie Vaes geeft oude liefde een tweede kans: “Speelt actieve rol in leven van Lio”

Snijd jij dagelijks op een plastic snijplank? Dit kan er dan gebeuren met je eten (en je lijf)

Dagboek van pedagogisch coach Imme: “Ik ga de moeilijke gesprekken niet uit de weg”

Babynamen Top 100 van 2025: dit waren de namen die ouders kozen

Horoscoop: wat brengen de sterren jouw kind in 2026?

Tussen de Lakens met Bo: “Geef mijn seksleven een 10 sinds ik moeder ben”

Weer een gebroken nacht? Dit doet structureel slaaptekort met je brein

Minder ruzie met je kind? Onderzoekers komen met deze verrassende oplossing

Jullie ergste kerstblunders: “Niemand haalde op tijd de wc”

De mooiste babynamen voor jouw kerstbaby

Spruitjesdrama aan tafel? Zo eten kinderen met kerst meer groente (zegt de wetenschap)

Michelle Bollen viert eerste kerst zonder kinderen: “Onafgebroken tranen”

Suzanne liep bij de voedselbank: “Ik at zelf minder zodat de kinderen genoeg hadden”

Weerupdate: kunnen we dan tóch de schaatsen pakken deze kerst?

Volgens de expert: waarom iedereen met kerst blijft scrollen (en hoe je dat samen aanpakt)

Zo beleeft jouw kind de feestdagen volgens zijn sterrenbeeld!

Op je zij, rug of buik? Dit is de beste slaaphouding tijdens je zwangerschap volgens de experts

Deze virale peutertekening liet duizenden moeders anders naar zichzelf kijken

Pyjama’s aan, dekentje erbij: dit zijn de leukste kerstfilms voor kinderen

Meisje van 2 bij keel gegrepen in supermarkt, ouders doen aangifte

Zoon van Klaasje Meijer geboren met een zeldzame slokdarmafsluiting: “Alles draaide om zorgen”

Dagboek van kinderuitvaartondernemer Amy: “Ik neem mijn werk altijd mee naar huis”

Belletje trekken loopt vreselijk mis: kind zwaargewond in Nijmegen

De laatste aflevering van Oogappels: Malou Gorter neemt afscheid van Merel

‘67’ is Kinderwoord van het Jaar, maar wat betekent het eigenlijk?

Joan Pronk over een bonusmoeder voor dochter Jazzy: “Dat idee vind ik gewoon raar”

Tussen de Lakens met Natalie: “De zin is er gewoon niet meer”

Vegetarisch opvoeden: kan dat eigenlijk wel als je kind nog groeit? Dit onderzoek geeft antwoord

Suzan en Freek delen nieuwe babyfoto’s! “De twee mooiste weken van ons leven”

“Houd hiermee op!”: Priscilla Wildeman van Een Huis Vol woest om valse overlijdensberichten

Nieuw onderzoek: je kind wordt stiekem socialer van dit huisdier

Wanneer kan mijn baby goed zien en kleuren herkennen?

Tekort aan deze vitamine? Dan krijgt je kind later vaker gaatjes, zegt nieuw onderzoek

Kind dat soms opbloeit en soms verdwijnt? Dan heb je misschien een Otrovert in huis

Deze moeders zien op tegen de kerstdagen: “Ik overleef vooral”

Het Huishoudboekje van Bo en haar gezin van zes: “Spaar geen centen, maar mooie momenten”

Buurvrouw slaat alarm bij Daisy in Vier Handen Op Eén Buik: ‘Hoest bloed op!”

Glennis Grace (47) wil weer een baby: ‘Eddy wil alleen met mij vader worden’

Zeven jaar na drama Oss: eindelijk begint de Stint rechtszaak

Douwe Bob herdenkt overleden zoon tijdens feestdagen: “Voor altijd bij ons”

Siamese tweeling gescheiden in Sydney: baby Tom overleeft operatie niet

Baby overleeft aanslag in buik van moeder, nu mag hij eindelijk naar huis

Hanna Verboom over het snel starten van een gezin: “Misschien hadden we iets meer tijd mogen nemen”

Ja, echt: kinderen worden blijer van minder cadeaus onder de boom, zeggen experts

Amber werd extreem te vroeg geboren: “Wil ouders niet bang maken, wel voorbereiden”

Donkere streep op je buik? Dit is waarom je die krijgt (en wanneer hij weggaat)

Bizar onderzoek: kan de geur van vet eten je baby al in de baarmoeder beïnvloeden?

Heftig: Hoofdpiet wordt nu met de dood bedreigd na Sinterklaasjournaal

Dagboek van kleuterjuf Floor: “De kinderen praten over niets anders dan het Sinterklaasjournaal”

Ook de koning en koningin maken zich zorgen om veiligheid dochters: “Altijd opletten”

Tieners die op deze leeftijd blowen lopen flink risico, zeggen experts

Familie Wildeman rouwt om dochter Lilly: “Je leeft door voor de andere kinderen”

Drie moeders over waarom zij geen sinterklaas vieren: “Teveel verdeeldheid”

Freek Vonk open over kinderwens: “Ik heb avontuur nodig”

Tussen de Lakens met Sanne (37): “Hij wil vaker seks in het donker, vindt hij me niet meer mooi?”

Schoonmoeder from hell: Monique Hansler knipt condooms van zoon door?

Nieuw in Groningen: een Stadsoppas waar je je kind een paar uur kan achterlaten

DIY Adventskalender: maak samen met je kind (+ gratis download!)

Ouders boos op Sinterklaasjournaal: “Jullie verklappen het geheim!”

Mama’s opgelet: met deze aanpak leert je baby makkelijker zelf in slaap vallen

Tranen gegarandeerd: oma’s reactie op geheime baby via draagmoeder gaat viral

Het perfecte speelgoed voor jouw kind per sterrenbeeld

Deze BN’ers duiken op in Het Sinterklaasjournaal: had jij ze al gespot?

Tessa is CliniClown: “We geven kinderen even de regie terug, in een wereld waarin alles voor hen wordt bepaald”

Let op – Primark haalt fopspenen terug: verstikkingsgevaar

Volgens onderzoek: waarom kinderen met deze vaardigheid ineens beter presteren (en relaxter zijn)

Bizar: man verkleedt zich als zijn overleden moeder om haar pensioen op te stelen

Het Huishoudboekje van Veerle en haar gezin van vier: “Zolang hij rookt, mag hij niets zeggen over mijn kosten”

Ben je een working mom? Zo werk jij na Equal Pay Day de rest van het jaar ‘gratis’

Irene Schouten over loodzware zwangerschap: “Ik hield alleen cola binnen”

Dit kwam naar voren in de eerste zitting van de rechtszaak rond Lisa (17)

Dit is het oordeel in de rechtszaak van de pleegouders uit Vlaardingen: “Ze had veilig moeten zijn”

Bizar: deze nieuwe wc-trend op scholen is te goor voor woorden

Artsen verbijsterd: 3-jarig jongetje lijkt genezen van ongeneeslijke syndroom van Hunter

Privégegevens van kinderen massaal gedeeld bij winactie Intertoys

Nieuwe trend: je dertienwekenecho in ChatGPT gooien om het geslacht te bepalen – slim of totaal niet?

Dit kenmerk uit je jeugd bepaalt hoe gevoelig je als ouder bent voor een burn-out

“Waarom is mama zo lelijk?” moeder stuit op een wel héél eerlijke vraag in zoekgeschiedenis

Vroege tandjes je baby? Volgens onderzoekers kan zwangerschapsstress meespelen

Oeps: moeder ontdekt gênante verrassing in peuter-rugzak

“Holy f*ck”: Barbara Sloesen ontdekte zwangerschap op het meest onverwachte moment ooit

Drama om snoepje van de juf: “Dit is waarom niemand meer wil lesgeven!”
Baby ‘shoppen’ op IQ en lengte? Deze nieuwe techniek is nu realiteit

Tussen de Lakens met Mara (51): “Ons kind zei: ‘Mama, hadden jullie ruzie vannacht?’”

Mikael (13) en zijn moeder mogen tóch in Nederland blijven

Gender reveal time: Danique Bossers onthult geslacht van baby nummer drie

Sinterklaas is dit weekend aangekomen: zo werd Dieuwertje Blok herdacht

Familie Kraan uit Een Huis Vol deelt babynieuws: “Er komt een klein Kraantje bij!”

Gender reveal! Channah Koerten onthult geslacht én naam na de geboorte

Wil je zien: Piloot stelt passagiers gerust met lief verhaal over dochter

Volgens de expert: waarom je je kind nooit bang moet maken met Sinterklaas

Emma Heesters kan niet meer zwanger raken: “Voelt oneerlijk”

Deze mislukte gender reveal-taart gaat viral (en wij liggen dubbel)

Dit is een butter mom (en waarom jij er een wilt zijn!)

Het Huishoudboekje van Sandra en haar gezin van vijf: “Door cashstuffen geen zorgen meer”

Celstraf geëist tegen ouders voor misbruik van kinderen in Apeldoorn

Kinderen in Haarlem beroofd en mishandeld door gemaskerde jongens tijdens Sint-Maarten

Dit helpt je baby direct ontspannen, zegt de wetenschap

Jessie Jazz Vuijk eerlijk over haar zwangerschap: “Voelde me vaak somber en alleen”

Deze oude favoriet is terug in het Sinterklaasjournaal (en hij komt je wel héél bekend voor)

Kinderen en snoep: hoe overleef je Sint-Maarten zonder ruzie?

Het Sinterklaasjournaal begint vandaag weer, mét dit nieuwe gezicht!

Julie Reinders verklapt babynaam: en die is next level uniek

Heftig: jongen met beperking tijdens Halloween zwaar mishandeld door leeftijdsgenoten

Moeder bevalt van een recordbaby: ‘Iedereen in de kamer hapte naar adem’

Van ‘je bent nog jong’ tot ‘ga lekker op vakantie’: wat vrouwen met een onvervulde kinderwens niet meer willen horen

Lidewij Welten gaf topsportcarrière op voor het moederschap: “Leef nu een nieuwe droom”

Die babybuik! Suzan en Freek delen prachtige nieuwe foto’s

Proces over het mishandelde pleegmeisje uit Vlaardingen: dit kwam naar voren op dag één

Studenten zamelen teddyberen in voor zieke kinderen: “Beschermengeltje voor kinderen die zich alleen voelen”

Dagboek van leerkracht speciaal onderwijs Anniek: “Een leerling kwam naar me toe met iets bruin en langwerpigs…”

‘Vriendin’ steelt zorgbudget van gezin met twee zieke kinderen, ouders moeten het zelf terugbetalen

Sterrenwijs: jouw kind is een Schorpioen (23 oktober – 21 november)

Lief: in dit filmpje hoort Lavezzi Rutjes dat zijn vader meedoet aan Wie is de Mol

Moeder van mishandeld pleegmeisje Vlaardingen spreekt voor het eerst: “Luister naar een kind”

Jacomien uit Urk! Geeft zwangerschapsupdate: “15 weken voor ons gehouden”

Tussen de Lakens met Noor: “ik had nog nooit gesquirt, schrok me kapot!”

Influencer zegt zwanger te zijn van Memphis Depay: “proberen dit op de beste manier op te lossen”

Oeps! Baby krijgt stempas in de bus, papa gaat ermee stemmen

Moet je je huilende baby direct oppakken of even wachten? Onderzoekers geven antwoord

Verrassend onderzoek: Zo helpt de stem van mama te vroeg geboren baby’s groeien

Dit nieuwe onderzoek over borstvoeding en borstkanker verrast wetenschappers

Co’s VBAC eindigde in een spoedkeizersnede: “Ik voelde aan alles: doe het niet”

Zoveel verschil maakt één extra week vaderschapsverlof voor je kind (zegt de wetenschap)

Een beetje eng, heel gezond: dit doet griezelen met je kind

Zwanger? Dit fruit mag je echt niet missen volgens diëtisten

Steeds meer meldingen van kindermishandeling (maar dat is niet alleen maar slecht nieuws)

Mag je iemand ontslaan die zwanger is? Deze zaak zorgde voor ophef

Het Huishoudboekje van Lisa en haar gezin van 11: “Proberen van weinig geld het mooiste te maken”

Alles over de rechtszaak tegen Marco Borsato: “Was een vaderfiguur en misbruikte dat vertrouwen”

Koppel nam hun baby van 9 maanden mee de bergen in… en kwam vast te zitten

Drie moeders over hun borstkanker: “Je moet door voor de kinderen”

Priscilla Wildeman van Een Huis Vol deelt verdrietig nieuws: zwangerschap moeten afbreken

Babynieuws! Vonneke Bonneke bevallen van tweede kindje

Yolanthe Cabau over kinderwens: “Veel moeite mee gehad”

Dagboek van kinderverpleegkundige en eigenaresse baby spa Eva: “zorgen voor de allerkleinsten is het mooiste wat er is”

Dit Halloween-kostuum past het beste bij je kind volgens het sterrenbeeld

Nieuw rapport: Nederland pakt geweld tegen vrouwen nog steeds niet hard genoeg aan

Telecombedrijf ontslaat alleenstaande moeder die goedkoper abbonement voor kinderen wilde regelen

Deze moeder steelt spotlight dochter tijdens gender reveal en krijgt bakken kritiek

Vrouw (22) zet zwangerschap in scène met pop: “Veel te ver gegaan”

Hun persoonlijkste nummer tot nu toe: Suzan & Freek delen nieuwe single ‘Niemand’

Verkiezingen 2025: dit willen de politieke partijen doen voor ouders en kinderen

Duitse vader schrikt zich rot: kind koopt voor 33.000 euro aan apps op iPad

Wintertijd en vroeg wakker? Zo pak je het aan volgens de expert!

Tussen de Lakens met Saskia: “We hadden een avontuurtje in het bos”

Het aantal kinderen zonder zwemdiploma verdubbelt: hoe kan dat?

Ouders opgelet: het kabinet waarschuwt voor dit online platform

Radio Veronica-DJ Lisanne Bronkhorst zwanger: “Ik deed de test bij de radio!”

Stille tocht in Terneuzen voor overleden moeder en dochter: “We voelen ons gesteund”

Win: Deel jouw bevallingsverhaal en maak kans op een verrassingspakket t.w.v. 150 euro!

Steeds meer kinderen worden bijziend “buitenspelen beste bescherming”

Onderzoek: Na een keizersnee meer risico op dit probleem

Moeder woedend na deze keiharde opmerking van juf op huiswerk van dochter

“Ik mag niet van haar gaan houden, dit gaat mis”: Susanne’s bevallingsverhaal

Moeder voorkomt misbruik van haar dochter (3): “Zo blij dat ik mijn gevoel heb gevolgd”

Martijn Krabbé wint Televizier-Ring: “Mijn kinderen zijn de moedigsten die er bestaan”

Babyfoon hacken? Zo makkelijk kunnen hackers meekijken met je baby

Onderzoekers ontdekken iets bijzonders over baby’s in de buik

Tienjarig meisje op fiets overleden na aanrijding in Tilburg

Peuter vindt granaat in tuin: “Mam, kijk eens wat ik heb gevonden!”

Het Huishoudboekje van Eva en Mark: “We hebben geen opvangkosten, opa’s en oma’s helpen mee”

“Ze zal altijd zijn tweelingzus zijn”: Tiffany over het verlies van haar baby

“Je geeft het geen plekje, je draagt het voor altijd met je mee”: Janneke over het verlies van haar baby

Yvette over het verlies van haar baby: “Het gemis gaat niet voorbij”

Drie moeders over het verlies van hun baby: “Je geeft het geen plek, je draagt het met liefde mee”

Nieuw onderzoek: in dure tijden wint deze supermarkt het van de rest

Doorbraak: nieuwe AI-test ontdekt borstkanker in beginstadium

Meeroken schadelijk voor kinderen: cijfers erger dan gedacht

Meisje (9) leert vader Engels: dit is het liefste wat je vandaag ziet

Het gedrag van je eerste kind na geboorte broertje of zusje zegt meer dan je denkt

Smaaktest voor griep: straks weet je via een kauwgom of je griep hebt

Moeder verslaafd aan telefoon: “gaf mijn scherm meer aandacht dan mijn kind”

Dagboek van leidinggevende op kinderdagverblijf Sanne: “Er gaat geen dag voorbij zonder dat er iets geks gebeurt”

Zee van bloemen in Terneuzen na overlijden moeder en dochter: “Er is veel verdriet”

Veel kinderen bang voor oorlog: “Ik wil het niet zien, maar het komt vanzelf voorbij”

Twee vrouwen ontdekken door DNA-test dat ze als baby’s zijn verwisseld

Ouders van baby die overleed aan ondervoeding hoeven niet terug de cel in

Man redt peuter uit gracht Amsterdam: “Ik sprong gewoon”

Kinderboekenweek 2025: dit is het thema en geschenk

Moeder stopt baby in wasmachine, kindje overlijdt

Mega-baby alert: Noud uit Zwolle weegt bijna 6 kilo

Schokkend: meeste kindermisbruikbeelden staan op Nederlandse servers

Astma voorkomen? Waarom een hond goed kan zijn voor je baby

Kinderen vertellen over scheiding? Expert: ‘Pas doen als je het zeker weet’

“Bel het alarmnummer”: kind schrijft briefje en redt zijn moeder

Dit simpele trucje helpt de hersenontwikkeling van je baby

Wanneer je baby een hartafwijking blijkt te hebben: Laura’s verhaal

Doorbraak embryo-onderzoek: baby uit huidcel?

“Mam, iedereen krijgt meer zakgeld dan ik!”: dit is normaal in 2025

Zwanger van een dochter: Welmoed Sijtsma vindt het “een extra uitdaging”

Mishandeling kind Schiedam: moeder ontdekt gebroken ribben bij zoontje (1)

Het Huishoudboekje van Ricco en Babette: “We genieten graag, maar wel met spaardoelen”

Kinderbijslag 2025 verhoogd! Dit bedrag krijg je vanaf deze maand uitbetaald

Sterrenwijs: jouw kind is een Weegschaal (23 september – 22 oktober)

Geen roze wolk: Erin vertelt over haar huilbaby

ChatGPT krijgt ouderlijk toezicht: filters, tijdslots en een noodknop

Bizar: ouders moeten 1.200 euro betalen voor tekeningen van hun kind

Schokkend: vrouw bevalt onverwacht terwijl proces over babymoord loopt

Opnieuw femicide: zwangere moeder doodgeschoten door partner

Deze baby heeft zóveel haar dat Elvis er jaloers op zou zijn

Van nul naar vijf in één klap: Theresa werd mama van een vijfling!

NS snapt het: extra pauzes en later beginnen als je last hebt van je cyclus

Kinderen onnodig uit huis: jeugdzorg schiet tekort

Onderzoek: zijn stellen die elkaar in het echt ontmoeten gelukkiger dan datingapp-koppels?

Paracetamol onder vuur: Trump zegt ‘niet slikken als je zwanger bent’

Poolse keten beloont koppels die baby verwekken in hun hotel

Plotselinge stijging wiegendood: hoe komt het dat meer baby’s onverwacht overlijden in hun slaap?

Baby van twee maanden opgesloten met broertjes en zusjes: “moesten eten uit de vuilnisbak”

Dit stel kreeg hun baby niet in het ziekenhuis, maar bij de McDonalds

Waarom pesters later vaker kinderen krijgen (en wat dit ons leert)

Voor het eerst meer kinderen met obesitas dan met ondergewicht

Schoolschandaal: moeder en dochter in relatie met dezelfde docent

Peuter slaat leidster… en zij slaat terug: de zaak die ouders bezighoudt

Vier jaar spoorloos in de wildernis: verdwenen kinderen Nieuw-Zeeland terecht

Zanger Paul de Munnik onthult in Beste Zangers groot babynieuws

Eerste baby’s krijgen prik tegen RS-virus

Zwangere vrouwen opgelet: dit risico loop je als je de kattenbak verschoont

Bijzonder: nieuwe zwangerschapstest speciaal voor blinden en slechtzienden

Van Storm tot Hazel: de mooiste herfstnamen voor je baby

Kinderopvang geeft opa per ongeluk verkeerd kind mee

Als zwanger worden langer duurt dan gehoopt: Yara’s verhaal

Baby geboren met een parasitaire tweeling in buik

Kinderen geen koopwaar: België wil commercieel draagmoederschap verbieden

Moeten bakfietsen straks écht van het fietspad af?

Waarom zwangerschapsstress meer invloed heeft op de huid van je baby dan je denkt

Alwéér voelen steeds meer jongeren zich eenzaam en gestrest, dit zijn de schokkende cijfers

Bizar: in Brazilië knuffelen moeders met levensechte babypoppen

Pijnlijk… bekende tennisser geeft kind zijn pet, deze man rooft het uit zijn handen

Na deze verschrikkelijke gebeurtenis met tiener komt ChatGPT met meer ouderlijk toezicht

Van K3 naar mama: Klaasje Meijer bevallen van eerste kindje

Babymoon vibes: Suzan showt groeiende babybuik op Ibiza

Deze moeder deelde een fout die haar baby bijna het leven kostte op TikTok

Wie zochten tijdens Corona vaker spanning buiten de deur: ouders of kinderloze stellen?

Sterrenwijs: jouw kind is een Maagd (23 augustus – 22 september)

Waarom zoveel ouders scheiden na de zomervakantie

“Onze dochter Fenna heeft een extreem zeldzame ziekte: we leven richting afscheid nemen”

Onderzoekers slaan alarm: Paracetamol en ibuprofen gevaarlijker dan je denkt

Van Portugal tot Ibiza: dit waren de vakantiebestemmingen van BN’ers

Griezelig: deze robot kan straks écht zwanger worden

Pedofiel betrapt in Plopsaland: filmde stiekem kinderen

Met een virale facebookpost redde deze papa de verjaardag van zijn dochter

Verschrikkelijk: Baby van 5 maanden overleden, vader wordt verdacht

Wat een nachtmerrie: baby een uur na de bevalling weggehaald door verboden test

Kinderen in de val: misbruik in geheime chatgroepen

Extra bescherming voor baby’s dit najaar: nieuwe RS-virusprik beschikbaar

De échte reden dat 9 op de 10 vrouwen cellulite krijgt

Onbewuste liefdesgeur? Zo beïnvloedt jouw lichaam mannen tijdens je ovulatie

Zo verpest je stiekem je kleding (en wat je beter kunt doen)

Geboren in dit seizoen? Dan heb je later meer kans op dipjes, volgens onderzoek

Waarom kinderen op het platteland minder last hebben van allergieën (en dit nieuwe onderzoek bewijst het)

Dit doet een plaknacht met je relatie (en je humeur)

Emoji over je kind plakken veilig? Experts zeggen van niet

IVF explodeert: miljoenen baby’s in amper 40 jaar tijd

Generaties vertrouwd, maar helemaal van nu: de nieuwe Zwitsal

Paniek in Breda: baby per ongeluk opgesloten in auto

Nieuwe mama? Deze Spotify-lijsten zijn perfect voor jouw baby

Moeder krijgt bizarre rekening nadat dochtertje (3) tafel breekt in ijssalon

Zoveel kosten de weekboodschappen van de familie Wildeman uit Een Huis Vol

Suzan & Freek geven zwangerschapsupdate: “Al ruim over de helft!”

Nachtmerrie in België: baby van 11 maanden in coma na drugs in flesje

Lange autorit voor de boeg? Zo voorkom je wagenziekte bij je kind

Schokkend: AI maakt van onschuldige kinderfoto’s misbruikmateriaal

Nooit meer zoeken: deze gratis kaart met 500+ kindvriendelijke horeca met speelruimte wil je nu opslaan

Gegevens van 485.000 vrouwen gestolen bij bevolkingsonderzoek baarmoederhalskanker

Deze familie uit Een Huis Vol stopt ermee…

Deze ChatGPT hacks gaan jouw leven als mama zoveel makkelijker maken!

Werkt een ijsje verkoelend? Zo hou jij je kind écht koel bij hitte!

Sterrenwijs: dit is de beste broer-zus match volgens het sterrenbeeld van je kind

Verontrustend onderzoek: deze populaire snacks verhogen het risico op longkanker aanzienlijk

Vakantie met kids: welk type moeder ben jij (echt)?

Dit zijn de meest opvallende babynamen van BN’ers

Een Huis Vol: familie Bal vangt kinderen op na groot verlies

Een wonder: baby geboren uit embryo van meer dan 30 jaar oud

Kinderwens? Dit moet je weten over zijn sperma en alcohol

Van bierviltje tot verandering: het ontstaan van Microkrediet voor Moeders

Ouders opgelet: dit zit er in zwembadwater…

Week van de Borstvoeding: dit zijn je rechten als je kolft op werk

Zegt de geboortedag van je kind iets over zijn toekomst?

Wat je wel en juist niet moet doen tijdens kraamvisite

Hoe ver zou jij gaan voor een grap? Deze baby-swap liep anders dan gepland

Bizar: dit is het vroegst geboren kindje ooit

Sterkste zaadcel wint? Nee hoor, ook hier doet de vrouw het werk

Even pijnlijk: dit onderzoek haalt een populaire vrouwen-mythe onderuit

Geen partner, wel een kinderwens: hoe zij moeder werd via co-ouderschap

Leerplicht vanaf vier jaar? Dit is wat er speelt

Zwanger tijdens een hittegolf? Dít helpt écht

Moeder en verslaafd – Deel 2: “De weg omlaag is veel sneller dan omhoog.”

Waarom je kind straks tóch geen sprinkhanen hoeft te eten

Niet zomaar mooi: deze babynamen hebben een spirituele boodschap

Je peuter meenemen naar een festival? Goed idee, zeggen onderzoekers!

Moeder en verslaafd – Deel 1: “Ik was bang de kinderen te verliezen, als ik het iemand vertelde”

PFAS in moedermelk en bij ongeboren baby: hoe zit dat nou echt?

Nederland zakt alwéér flink op de ranglijst voor kinderrechten

Originele Vaderdagcadeaus voor papa’s die alles al hebben!

Vroeggeboorte: “Drie maanden te vroeg braken mijn vliezen”

“Er zou twee weken rouwverlof moeten komen na een miskraam.”

Trakteren op school



